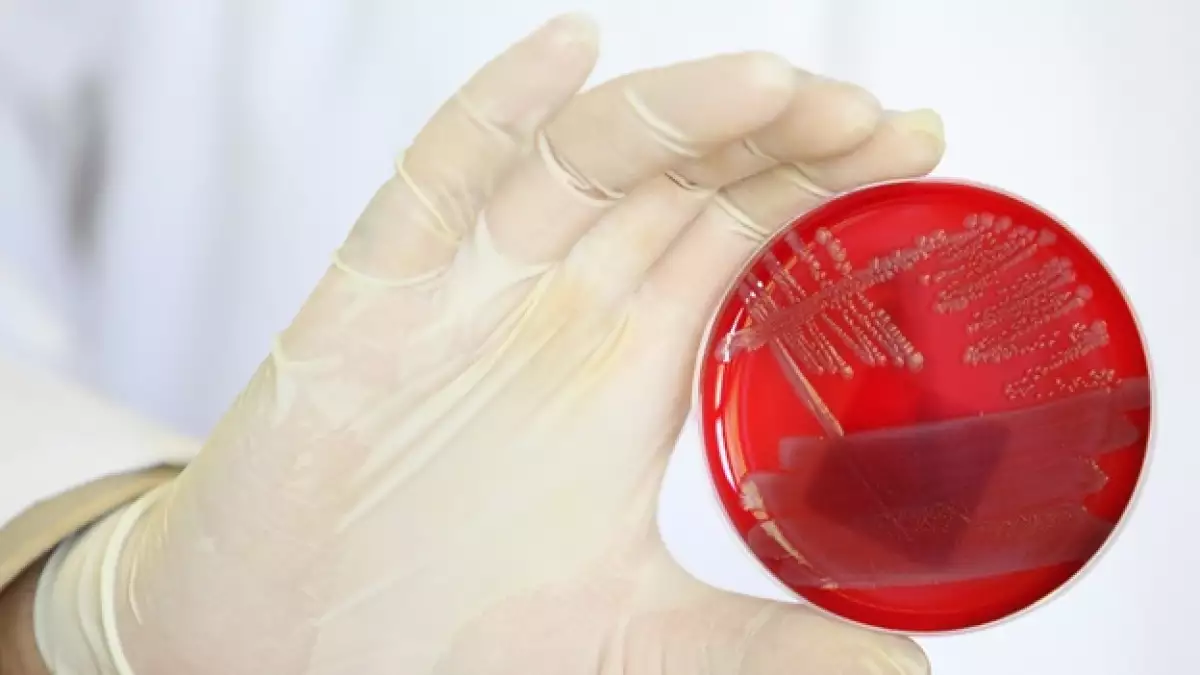

Agencia europea señala vínculo de semillas de Egipto con la 'E. coli'
Un grupo de trabajo de la Agencia Europea de Seguridad Alimentaria (EFSA) concluyó que un lote de semillas de fenogreco (alholva o heno griego) importado de Egipto y utilizado para producir brotes son el vínculo común "más probable" entre los brotes de E. coli en Francia y Alemania, indicó la dependencia este martes, en un comunicado.
Los brotes recientes en Europa han dejado 48 muertos en Alemania y uno en Suecia, señaló la agencia.
La EFSA dijo que 4,178 casos han sido reportados en la Unión Europea, Noruega y Suiza.
El brote comenzó en mayo en Alemania, mientras que en Francia, en la región de Bordeaux, se reportó el 24 de junio, según la agencia alimentaria, que ofreció consejos de alimentación para los consumidores.
"Las semillas para germinados son vendidas como mezclas con alimentos contaminados, por lo que no pueden ser excluidos. Es importante recomendar a los consumidores que no hagan germinados para su propio consumo, y que no los coman sin haberlos cocinado", informó el comunicado.